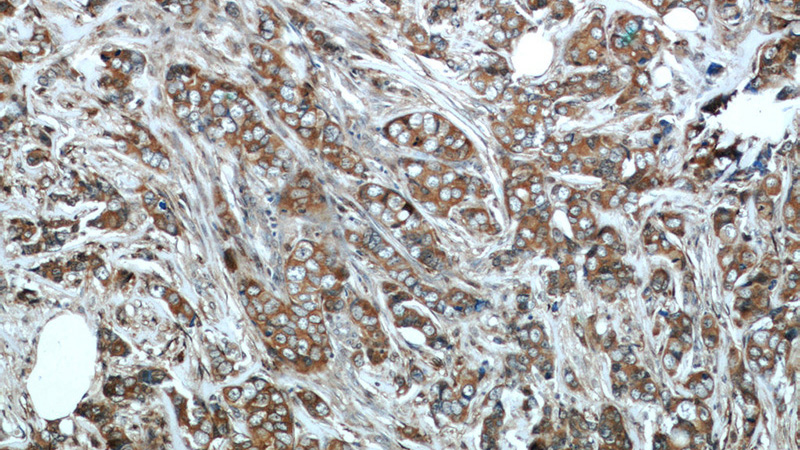
Immunohistochemical of paraffin-embedded human breast cancer using Catalog No:113023(NBR1 antibody) at dilution of 1:50 (under 10x lens)
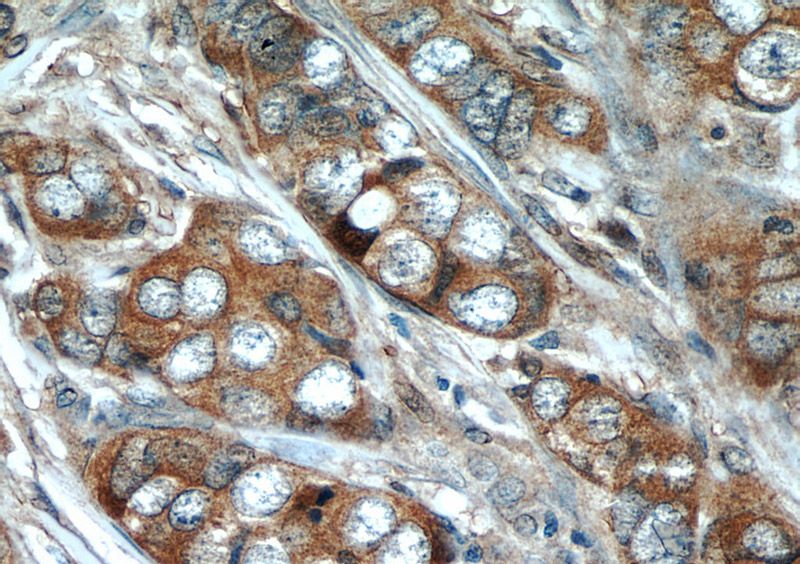
Immunohistochemical of paraffin-embedded human breast cancer using Catalog No:113023(NBR1 antibody) at dilution of 1:50 (under 40x lens)
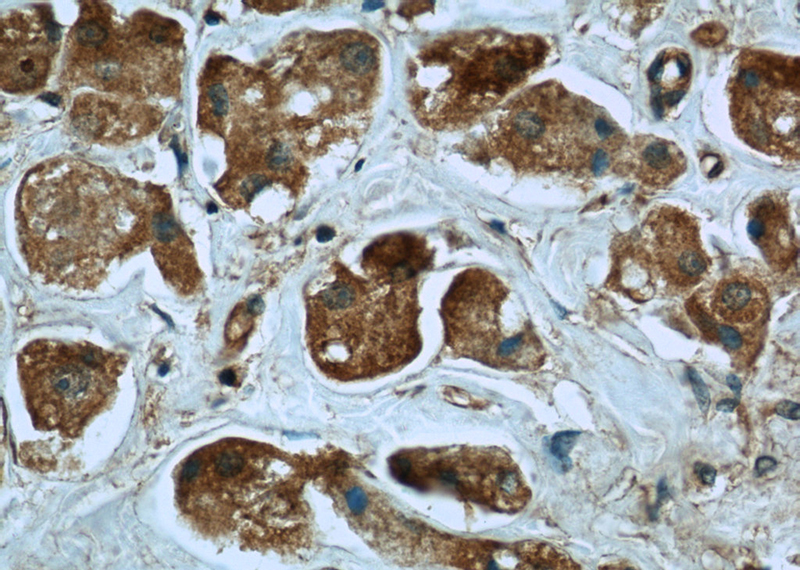
Immunohistochemistry of paraffin-embedded human breast cancer slide using Catalog No:113023(NBR1 Antibody) at dilution of 1:50

-
Product Name
NBR1 antibody
- Documents
-
Description
NBR1 Rabbit Polyclonal antibody. Positive WB detected in HeLa cells, A2780 cells, COS-7 cells, HepG2 cells, Jurkat cells, MCF7 cells. Positive IP detected in HeLa cells. Positive FC detected in HeLa cells. Positive IF detected in Hela cells. Positive IHC detected in human breast cancer tissue, human heart tissue, human skeletal muscle tissue. Observed molecular weight by Western-blot: 140 kDa
-
Tested applications
ELISA, WB, IHC, IF, IP, FC
-
Species reactivity
Human,Mouse,Rat, Monkey; other species not tested.
-
Alternative names
1A1 3B antibody; 1A13B antibody; FLJ55359 antibody; FLJ98272 antibody; KIAA0049 antibody; M17S2 antibody; MIG19 antibody; NBR1 antibody; neighbor of BRCA1 gene 1 antibody; Next to BRCA1 gene 1 protein antibody; Protein 1A1 3B antibody
-
Isotype
Rabbit IgG
-
Preparation
This antibody was obtained by immunization of NBR1 recombinant protein (Accession Number: NM_001291571). Purification method: Antigen affinity purified.
-
Clonality
Polyclonal
-
Formulation
PBS with 0.02% sodium azide and 50% glycerol pH 7.3.
-
Storage instructions
Store at -20℃. DO NOT ALIQUOT
-
Applications
Recommended Dilution:
WB: 1:200-1:2000
IP: 1:200-1:2000
IHC: 1:20-1:200
IF: 1:10-1:100
-
Validations

HeLa cells were subjected to SDS PAGE followed by western blot with Catalog No:113023(NBR1 antibody) at dilution of 1:1500

IP Result of anti-NBR1 (IP:Catalog No:113023, 4ug; Detection:Catalog No:113023 1:800) with HeLa cells lysate 2500ug.
Immunohistochemical of paraffin-embedded human breast cancer using Catalog No:113023(NBR1 antibody) at dilution of 1:50 (under 10x lens)
Immunohistochemical of paraffin-embedded human breast cancer using Catalog No:113023(NBR1 antibody) at dilution of 1:50 (under 40x lens)
Immunohistochemistry of paraffin-embedded human breast cancer slide using Catalog No:113023(NBR1 Antibody) at dilution of 1:50

Immunofluorescent analysis of Hela cells, using NBR1 antibody Catalog No:113023 at 1:25 dilution and Rhodamine-labeled goat anti-rabbit IgG (red).

1X10^6 HeLa cells were stained with 0.2ug NBR1 antibody (Catalog No:113023, red) and control antibody (blue). Fixed with 90% MeOH blocked with 3% BSA (30 min). Alexa Fluor 488-congugated AffiniPure Goat Anti-Rabbit IgG(H+L) with dilution 1:1500.
-
Background
NBR1, also named as 1A13B, KIAA0049 and M17S2, acts probably as a receptor for selective autophagosomal degradation of ubiquitinated targets. NBR1 and P62 can bind to autophagic effector proteins (Atg8 in yeast, MAP1LC3 protein family in mammals) anchored in the membrane of autophagosomes. It is a highly conserved multidomain scaffold protein with proposed roles in endocytic trafficking and selective autophagy. NBR1 is a novel PB1 adapter in Th2 differentiation and asthma. It functions as an autophagy receptor involved in targeting ubiquitinated proteins for degradation. It also has a dual role as a scaffold protein to regulate growth-factor receptor and downstream signaling pathways.
-
References
- Odagiri S, Tanji K, Mori F, Kakita A, Takahashi H, Wakabayashi K. Autophagic adapter protein NBR1 is localized in Lewy bodies and glial cytoplasmic inclusions and is involved in aggregate formation in α-synucleinopathy. Acta neuropathologica. 124(2):173-86. 2012.
- Mori F, Tanji K, Odagiri S. Autophagy-related proteins (p62, NBR1 and LC3) in intranuclear inclusions in neurodegenerative diseases. Neuroscience letters. 522(2):134-8. 2012.
- Tanji K, Zhang HX, Mori F, Kakita A, Takahashi H, Wakabayashi K. p62/sequestosome 1 binds to TDP-43 in brains with frontotemporal lobar degeneration with TDP-43 inclusions. Journal of neuroscience research. 90(10):2034-42. 2012.
- Mori F, Watanabe Y, Miki Y. Ubiquitin-negative, eosinophilic neuronal cytoplasmic inclusions associated with stress granules and autophagy: an immunohistochemical investigation of two cases. Neuropathology : official journal of the Japanese Society of Neuropathology. 34(2):140-7. 2014.
- Satoh J, Motohashi N, Kino Y. LC3, an autophagosome marker, is expressed on oligodendrocytes in Nasu-Hakola disease brains. Orphanet journal of rare diseases. 9:68. 2014.
- Walter KM, Schönenberger MJ, Trötzmüller M. Hif-2α promotes degradation of mammalian peroxisomes by selective autophagy. Cell metabolism. 20(5):882-97. 2014.
- Suzuki S, Uchida K, Harada T. The origin and role of autophagy in the formation of cytoplasmic granules in canine lingual granular cell tumors. Veterinary pathology. 52(3):456-64. 2015.
- Mandelbaum J, Rollins N, Shah P. Identification of a lung cancer cell line deficient in atg7-dependent autophagy. Autophagy. 2015.
Related Products / Services
Please note: All products are "FOR RESEARCH USE ONLY AND ARE NOT INTENDED FOR DIAGNOSTIC OR THERAPEUTIC USE"
